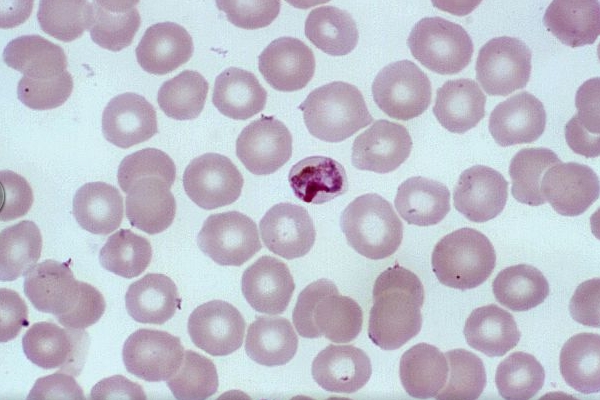

<여성 방광염 증상과 원인>
건강보험심사평가원에 따르면 지난해 방광염으로 병원 진료를 받은 환자 수는 156만여 명이며, 이중 약 95%가 여성이라고 합니다. 방광염은 치료가 제때 이뤄지지 않거나 자주 재발하면 만성 방광염으로 진행될 위험이 있기 때문에 일찍 발견해 치료를 시작해야 합니다. 소변을 볼 때 찌릿한 통증이 느껴지거나, 소변에서 냄새가 나는 등의 증상이 있으면 방광염을 의심해 볼 수 있는데요. 오늘은 방광염의 증상과 원인을 함께 알아보겠습니다.
•방광염
방광에 감염이 발생한 것을 뜻하며 방광 내 세균이 비정상적으로 증식하여 발생합니다. 급성 방광염은 요로계의 해부학적, 기능적 이상 없이 세균이 침입하여 발생한 감염으로 인해 염증이 방광 내에 국한되어 나타나고 다른 장기에는 염증이 없는 질환입니다. 만성 방광염은 통상적으로 1년에 3회 이상 방광염이 발생하는 경우를 말하며, 지속적인 또는 완치되지 않은 방광염을 의미합니다.

•방광염 증상
-배뇨 중 통증, 작열감
-갑작스럽게 느끼는 요의
-소변의 양은 적으나 요의를 자주 느낌
-하복부의 통증
-혈액이 섞인 소변
-탁한 소변 색
-강하거나 불쾌한 냄새가 나는 소변
•방광염의 원인
-심한 스트레스와 과로
심한 스트레스와 과로는 면역력을 저하해 방광염 감염의 원인이 될 수 있습니다.

-생리 전후
월경을 할 때는 자궁입구가 열리게 되어 세균이 침투하기 쉬워집니다. 또한 월경 중에는 자궁이 약산성을 유지하는 평소와 달리 질 내에 알칼리성 혈액이 고여 있기 때문에 세균이 쉽게 자라날 수 있는 여건이 된다고 합니다.

-성관계
또한 콘돔의 재질 역시 여성의 요로 점막을 자극할 수 있다고 하는데요. 방어 기능을 약하게 하여 세균이 증식하게 하는 것입니다. 성관계 후 방광염을 유발하는 가장 큰 요인 중 하나는 성관계 후 여성의 위생 상태입니다. 관계가 끝난 즉시 소변을 보지 않으면 성관계로 침투한 박테리아가 방광에서 증식할 확률이 더욱 커질 수 있습니다.

성관계로 인한 요도 외상도 방광염의 원인이 될 수 있습니다. 성관계는 여성의 요로를 약하게 만들어 외부의 세균이 침입하게 하고 요도의 면역력을 낮춘다고 합니다. 그리고 생리 중에 성관계를 하게 되면 골반 내로 세균이 침투해 골반염이나 방광염을 일으킬 위험성이 커진다고 합니다.
-피임약 장기 복용
피임약 성분은 몸의 면역력을 약하게 한다고 하는데요. 호르몬제, 피임약 등은 나쁜 콜레스테롤인 LDL은 높이고 좋은 콜레스테롤인 HDL의 수치를 낮춥니다. 또 장속의 좋은 유익균인 유산균을 죽이기 때문에 장 건강에도 문제를 일으킬 수 있다고 합니다.

-완경기 이후의 여성
여성의 완경기 이후에는 여성호르몬인 에스트로겐 호르몬이 감소하면서 방광의 방어력이 떨어지게 되므로 방광염에 걸릴 위험이 증가한다고 합니다.

-소변의 세균 증식 촉진하는 당뇨병 환자의 당 성분이 많은 소변
당뇨병 환자는 정상인에 비해 3~4배 정도 요로 감염의 위험이 높은 것으로 알려져 있습니다. 이는 면역력이 떨어져 세균 침입을 조절할 수 있는 능력이 떨어지고 소변으로 배출되는 포도당이 세균 증식에 영향을 미치는 것이 주요 원인으로 꼽힙니다.

•방광염이 유발하는 질환
-만성 방광염
면역력이 떨어지고 염증 회복 속도가 더디면 쉽게 치료가 될 방광염도 치료 기간이 오래 걸리고 만성 방광염으로 발전하는 경우가 많습니다. 치료가 지연되고 만성이 되면 방광의 점막 깊이 궤양이 생기고 반복된 상처로 방광 근육층이 비후 되고 섬유화 되어 방광이 딱딱해진다고 합니다.
-신우신염
신우신염은 세균에 의한 신장의 염증상태를 의미하는 것으로 대부분 방광에서부터 균이 신장으로 거슬러 올라가 발생하는 질환입니다. 신우신염은 20~50대 여성에게 흔하게 발생하는데, 신우신염의 원인인 방광염의 발생 또한 20~50대 여성에게 흔하기 때문입니다.
2020/04/26 - [건강] - 소변에 거품이 나는 이유
소변에 거품이 나는 이유
<소변에 거품이 나는 이유> 소변을 보는데 어느 날 거품이 많았던 적 있나요? 정상적인 사람일 경우, 소변을 볼 때 거품의 양이 적거나 곧바로 사라집니다. 하지만 몸에 이상이 있을 때는 그 신호로 소변에서 거품..
2020.miecn.xyz
-요로 감염
비뇨기계의 한 부분에 세균이 들어가 소변 속에서 번식하게 된 것을 요로 감염이라고 합니다. 방광염의 원인균 대부분이 대장균이며, 감염 경로는 요도로부터 방광으로 올라가는 상행성 감염이 있습니다. 여성은 상대적으로 짧은 요도를 가지기 때문에 남성보다 여성에게서 빈번하게 발생합니다.
-요로결석
요로 결석 형성의 원인으로 탈수와 방광염이 관여한다고 하는데요. 요로결석이란 소변이 만들어져 수송, 저장, 배설되는 길에 결석이 생긴 것을 말합니다. 돌이 생기는 곳에 따라 신장 결석, 요관 결석, 방광 결석, 요도 결석 등으로 나뉩니다.

•방광염의 치료
-물 자주 마시기
매일 최대한 물을 많이 마시도록 합니다. 그래야 방광을 포함한 요로계에 번식한 박테리아를 씻어내는 데 도움이 됩니다.

-설탕이 함유된 음료 및 자극적인 음료 피하기
차나 커피와 같이 카페인이 포함된 음료는 방광 내부의 점막을 자극할 수 있습니다. 방광염을 야기하는 박테리아는 방광 점막에 몸을 부착시켜 염증을 일으키기 때문에 카페인 섭취 시 느끼는 통증이 가중될 수 있습니다. 따라서 방광 점막을 추가적으로 자극할 우려가 있는 음료를 피해 통증 발생을 막고 회복을 촉진하도록 해야 합니다.

-치료 중 성관계 자제하기
성관계는 방광염 치료를 늦추기도 하고, 오히려 방광염을 악화시킬 수 있습니다. 방광염이 다 나을 때까지 성관계는 가지지 않는 것이 좋습니다.

-소변 참지 않기
배뇨감이 들면 장시간 참지 않도록 해야 합니다. 잦은 배뇨는 방광의 노폐물과 세균을 지속적으로 배출해 줍니다.
-항생제 복용
항생제는 실제로 감염이 발견되었을 때만 처방되는 약입니다. 처방받은 항생제는 끝까지 복용해야 합니다. 증상이 완화되었다고 도중에 끊어버리면 증상이 재발할 수도 있습니다.

-금주
술 역시 면역력 저하의 원인이 됩니다. 술 때문에 방광염 치료가 더뎌질 수 있으므로 방광염 치료 중에는 금주를 하는 것이 좋습니다.


-비타민C 섭취
비타민C는 항산화 비타민으로 면역력을 높이고, 점막을 튼튼하게 합니다. 이는 과일과 야채에 다량 함유되어 있으므로 신선한 과일과 야채의 섭취는 방광염의 치료에 도움이 됩니다.
이상으로 여성 방광염 증상과 원인에 대해서 살펴보았습니다. 도움이 되는 정보였다면 아래의 공감 버튼을 한번 꾹 눌러주세요. 오늘도 활기차고 유익한 하루 보내시길 바랍니다. 행복하세요
'건강' 카테고리의 다른 글
| 피부가려움증 두드러기 치료방법 (0) | 2020.05.09 |
|---|---|
| 우엉차 효능 부작용 (0) | 2020.05.08 |
| 공복혈당 낮추는 음식 (0) | 2020.05.06 |
| 머리숱 많아지는법 (0) | 2020.05.05 |
| 과민성 대장증후군 증상 (0) | 2020.05.03 |
댓글